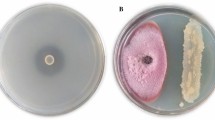

Abstract
Modernization has introduced intensive agricultural practices wherein the pesticides play an important role both in stabilization and in increase of agricultural products. As a consequence, humans and members of other ecosystems are exposed to increased levels of compounds that have detrimental effects on their health, thereby signifying the importance of microbial inoculants. In order to achieve this goal 7 different bacterial species were initially screened for isolation of plant growth-promoting Bacillus sp. The isolate CUAMS116 was confirmed to be Bacillus cereus through biochemical and molecular characterization. The in vitro plant growth-promoting ability of the isolate was screened through standard tests. Different concentrations of bacterial inoculant (25%, 50%, 75%, 100%) were evaluated for its plant growth promotion ability using Phaseolus vulgaris L., under pot culture conditions. At the harvest stage, the mature control plants measured 16.53 cm and mean treated plant height was measured to be 27.75 cm, showing a maximum percentage increase in length of 67.87%. The results suggested that the B. cereus CUAMS116 isolated in this study can be extended as a PGPM through further field trials in other plants for improving crop yield and tolerance to biotic and abiotic stresses.
Similar content being viewed by others
Avoid common mistakes on your manuscript.
1 Introduction
Rhizosphere encompasses the narrow zone of soil directly surrounding the root system of plants [1]. Groups of rhizosphere bacteria that are competent in colonizing the root environment are referred to as rhizobacteria [2]. The plants have evolved with a plenitude of micro-organisms with diverse functional potential [3]. Plant growth-promoting micro-organisms (PGPMs) are primarily found existing in the rhizosphere. They are characterized by the presence of different root secretions and intense microbial activity [4]. Root colonization involves one of the major processes which determines the survival of the bacteria after inoculating the seeds or soil. The bacterial multiplication happens in the spermosphere, in case of germinating seeds, stimulated by the carbohydrate and amino acid rich seed exudates [5]; similarly, they cling to the root surface and colonize the root system that develops further. The microbes, both beneficial and harmful, make their way into the plants mainly through their water and nutrient absorption channels. Reviews suggest an increase in microbial population inside roots than the outside. Thus, the efficiency of inoculated rhizobacteria depends also on its ability to outcompete the competitors of the root zone, displacing the native root-colonizing microbiota [6]. This persists through the mid-stages of the host plant ontogeny at population densities of Log 3 to Log 6 cfu/g root fresh weight [2, 7, 8].
The uptake of essential compounds, mediated by the interaction between micro-organism and roots, helps to prevent the accumulation of toxic compounds [9]. The basic mechanisms that are being relied on by PGPMs which in turn can contribute to the increase of nutrient uptake are nitrogen fixation and phosphate solubilization. In addition to these, they can produce various siderophores, plant hormones, lytic enzymes and cyanides. These compounds are considered to exhibit a phytostimulant effect on the plants and can function as rhizomediators and biopesticides [10]. Subhashrao (2012) reports PGPM to be generally indigenous to plant rhizosphere and the soil ecosystem, where they suppress a broad spectrum of bacterial, fungal and nematode diseases as well as provide protection against viral diseases.
An ideal soil microbial inoculant could be better defined as a genetically stable species which can effectively and predictably establish in a wide range of environments, soil conditions and crop cultivars, performing the targeted functions without extending its colonization farther from the site of application. A microbial inoculant should ideally persist only through targeted functional periods without directly affecting human health by producing secondary metabolites or the environment by suppressing the indigenous taxa population [11].
The enhancement of nutrient status of the host plant by a PGPM is basically dependent upon the extent of proximity existing among them. This, in turn, can vary considering the region of colonization of the host plant, as well as the mechanism the microbe adopts. Two levels of complexity can be assigned based on the relationship between the PGPM and the host plant—(1) endophytic and (2) rhizospheric. The endophytic genera like Pseudomonas, Azospirillum, Acetobacter, Herbaspirillum, Bacillus etc. inhabit mainly the inner tissues of roots. Microbes colonizing root caps are benefited by the mucilage it produces that helps in preventing desiccation, promotes adherence to soil and provides a nutrient source. Similarly, during colonization of epidermis and root hairs, the bacteria produce mucilage that is similar to pectin, which helps in penetration of the cells [12].
The rhizospheric bacteria can also be categorized as (1) generalists and (2) specialists, depending on their ability to utilize several substitutable resources in a complex environment. The substitutable substrates refer to those substrates that are able to support the growth of the microbe in any of its forms. For example, sugars, organic acids and many other compounds can act as the carbon source. Generalists usually are able to thrive on many of these different forms, depending on the availability. Thus, depending on the availability of particular substrates and the type of microbial community present, competition, evolution or exclusion can take place [13].
Authentic growth-regulating substances applied once to seeds or seedlings affected subsequent plant development. Therefore, bacterial inoculants supplying growth hormones and applied once could also cause changes in plant growth without necessarily continuously multiplying and producing more hormones in the rhizosphere. All inoculants multiplied around seedling roots and are expected to produce growth regulators critical stages of growth. The magnitude of the plant response in turn is undoubtedly to be influenced by the amount of hormone produced and the environmental conditions, such as plant species, soil fertility, day length, light intensity, soil moisture, temperature and length of growing season [14].
Many Bacillus species have been known to induce plant growth promotion and have found a wide application in microbial inoculant formulations. Bacillus cereus AR156 is being reported to induce resistance against a broad spectrum of pathogens including Pseudomonas syringae pv. tomato DC3000 and induced systemic resistance (ISR) to DC3000 in Arabidopsis ecotype Col-0 plants [15, 16]. Inoculation of B. cereus had significantly increased proline, antioxidant enzymes, phytohormones and yield attributes of cultivated species in saline sodic field by salinity alleviation [16, 17].
Various in vitro and in vivo trials have revealed that most of the times these are not directly correlated i.e. certain strains showing multiple growth-promoting traits in vitro would show insignificant effects in growth and productivity once greenhouse or field trials were conducted and [18], strain that showed positive for only one trait exhibited high growth promotion efficacy. These observations and identification of effective strains solely depending upon but in vitro physiological assays are unreliable for strain selection and pot tests on multiple crop plants is preferable [18].
Bacillus members have been widely studied as pathogens and environmental strains of industrial, ecological and medical relevance. Studies have reported the production of various valuable enzymes and metabolites that degrade different types of pollutants, and promote the growth of animals and plants by B. cereus group when used as probiotics. A comprehensive analysis, using a comparative genomics approach, pertaining to the characteristics of B. cereus related to agriculture had not been reported much [19].
Microbial-based inoculants are seen to show profound interaction with nitrogen cycle. They can either reduce or increase the N2O emissions under fertilized and unfertilized conditions. Although the elucidation of the specific conditions which favour the interaction and mechanism of reducing N2O emissions by microbes and microbial metabolites has not been much worked on, there are noteworthy findings that stimulate the expansion of further research in the potential of microbial inoculants to lower the excessive loss of nitrogen from agricultural systems [19, 20].
The present study focuses mainly on the isolation of a plant growth-promoting bacterial species from soil, its biochemical and molecular characterization and assessing plant growth influenced by the isolate.
2 Materials and Methods
2.1 Isolation of Bacillus sp. from Soil
Garden soil samples from the rhizosphere of healthy bean plants were collected from Madiwala, Bangalore, Karnataka, India. One gram of soil sample was heated to 60 °C for 30 min to eliminate nonsporulating bacteria (for selective isolation of Bacillus sp.) and added to 100 ml of sterile distilled water and serially diluted till 10−6 dilution. In total, 0.1 ml of each dilution was spread plated onto sterile nutrient agar media (contained (w/v) peptone 0.3%, sodium chloride 0.5%, yeast extract 0.3%, agar 1.5%, distilled water 100 ml, pH 7). All the plates were incubated at 37 °C for 24–48 h [21]. After incubation, the colonies were observed for their colony morphology and gram staining nature. Gram-positive rods were selected and subcultured on nutrient agar plates for further experiments.
2.2 Biochemical Tests
Preliminary characterization of the isolate prior to molecular characterization was done using various standard biochemical tests [21].
2.3 In Vitro Screening for Growth-Promoting Traits
2.3.1 Siderophore Production Test
An overnight nutrient broth (contained (w/v) peptone 0.3%, sodium chloride 0.5%, yeast extract 0.3%, distilled water 100 ml, pH 7) culture of the tested isolate was taken and centrifuged at 10,000 rpm for 10–20 min. To the supernatant obtained, 5 ml of 2% FeCl3 solution was added. This was observed for the formation of red/purple colouration which signifies a positive result [22].
2.3.2 Indole Acetic Acid (IAA) Production Test
In total, 1% aqueous solution of tryptone and tryptone broth (contained (w/v) tryptone 1%, NaCl 0.5%, distilled water 100 ml, pH 7.5 ± 0.2) was dispensed into sterile test tubes and autoclaved. Into the former solution, the test culture was inoculated and latter was maintained as control. The tubes were incubated for 24 h and 1 ml Kovac’s reagent. The alcohol layer was separated from aqueous layer upon standing and a rendering of alcohol layer from tryptone broth within a few minutes. If this produces a cherry red layer test, it is taken positive for indole [23].
2.3.3 Phosphate Solubilization Test
Phosphate solubilization test was performed by simple streak inoculation of test organism on Pikovskaya’s medium (contained (w/v) glucose 0.1%, magnesium sulphate heptahydrate 0.1%, calcium chloride 0.1%, TCP 0.5%, yeast extract 0.05%, agar 0.2%, distilled water 100 ml, pH 7.0). The plates were incubated at 28 ± 1 °C for 4–5 days. Formation of a clear inhibition zone around the colony was considered positive for phosphate solubilization [24].
2.3.4 Bioassay Against Fungal Pathogens
Fungal pathogens were grown on a potato dextrose agar (PDA) (contained (w/v) potato (infusion form) 20%, dextrose 2%, agar 1.5%, distilled water 100 ml, pH 5.6 ± 0.2) plate till it covered the whole surface of the agar. With the help of sterile cork borer, a disc of fungal growth from this plate was taken and placed at the centre of the fresh PDA plate. The test bacterial strain was then streaked parallelly on either side of the fungal disc and kept for incubation at 30 °C for 96 h. Observations on the inhibition of growth of fungal pathogen were recorded after 96 h of incubation in comparison with the PDA plate inoculated with only the pathogens [25].
2.3.5 Test for Cellulase Production
Carboxy methyl cellulose (CMC) agar (contained (w/v) carboxymethyl cellulose 0.2%, sodium nitrate 0.1%, dipotassium phosphate 0.1%, potassium chloride 0.1%, magnesium sulphate 0.05%, ferrous sulphate 0.001%, yeast extract 0.5%, agar 1.5%, distilled water 100 ml, pH 7.2 ± 0.2) media were prepared, autoclaved and poured into sterile Petri plates. This was inoculated with test culture and incubated for 48 h at 37 °C. After the completion of incubation, the plates were treated with 0.1% Congo red solution and NaCl solution sequentially to visualize the zone of clearance [26].
2.3.6 Test for Hydrogen Cyanide (HCN) Production
The test bacteria were streaked on King’s B medium (contained (w/v) peptone 1.6%, dipotassium hydrogen phosphate 0.16%, magnesium sulphate 0.16%, glycerol 1%, agar 2%, distilled water 100 ml, pH 7.2 ± 0.2) amended with glycine at 4.4 g/l. Sterile filter paper saturated with picric acid solution (2.5 g of picric acid; 12.5 g of Na2CO3, 1000 ml of distilled water) was placed in the upper lid of the Petri plate. The dishes were sealed with parafilm and incubated at 28 °C for 48 h. A change of colour of the filter paper from yellow to light brown, brown or reddish-brown was recorded as weak (+), moderate (++) or strong (+++) reaction, respectively [27].
2.3.7 Test for Ammonia Production
Bacterial isolates were tested for the production of ammonia in peptone water following the method of Ahemad and Kibret [28]. Freshly grown cultures were inoculated in 10 ml peptone water (contained (w/v) peptone 1.0%, sodium chloride 0.5%, distilled water 100 ml, pH 7.2) in each tube separately and incubated for 48–72 h at 28 ± 2 °C. Nessler’s reagent (0.5 ml) was added in each tube. Development of brown to yellow colour was a positive test for ammonia production [28].
2.4 16S rRNA Sequencing
Genomic DNA isolation and molecular characterization of the selected plant growth-promoting bacterial isolate were carried out at Barcode Biosciences (Bangalore, Karnataka, India). Genomic DNA from the bacteria was isolated using GeneiPure™ bacterial DNA purification kit (GeNei™, Bengaluru, India) according to the manufacturer’s protocol. Universal eubacterial primers F-D1-5′-ccgaattcgtcgacaacagagtttgatcctggctcag-3′ and R-D1-5′-cccgggatccaagcttaaggaggtgatccagcc-3′ [29] were used to amplify the 1500-bp region of 16S rRNA gene using BDT v3.1 Cycle sequencing kit in a thermal cycler (BioRad, USA). The amplified DNA was then visualized through agarose gel electrophoresis (1% agarose) followed by using gel documentation system. The purified partial 16S rRNA amplicon was sequenced in ABI 3730xl Genetic Analyzer. The 16S rRNA gene sequence was used to carry out BLAST with the ‘nr’ database of NCBI GenBank database. Based on maximum identity score first ten sequences were selected and aligned using multiple alignment software program CLUSTAL W. Distance matrix was generated using RDP database, and the phylogenetic tree was constructed using MEGA 6 software (details given as supporting data material).
2.5 Greenhouse Trials
Bioefficacy of the sequenced isolate was further confirmed by conducting pot culture assay with shrub beans (Phaseolus vulgaris L.) as the test crop. After surface sterilization, in 0.2% HgCl2 for 5 min followed by ten times washing with sterile tap water, the seeds were first sown in protrays containing moist cocopeat. Each well contained 1 seed sown at 2 cm depth [14].
Pot trials were conducted in nonautoclaved soil, under greenhouse conditions. The seedlings were transplanted to clay pots of 22.7 cm diameter and 4 kg of soil at 2-leaf stage. Ten replications were maintained for all the treatments. Red soil and organic manure were mixed in a 3:1 ratio to prepare the potting mixture [30].
Seeds were treated with liquid bioinoculants in different combinations (Table 1) at the rate of 5 ml of liquid inoculant per treatment. Pure culture of the strain was grown in NB at 37 °C and diluted to a final concentration of 108 cfu/ml with sterile distilled water and inoculated the transplanted seedlings in the 2-leaf stage (one plant per pot). Control seedlings were treated with sterile distilled water. The moisture content of the soil was maintained at 50% of its water-holding capacity. The plants were harvested after 45 days of emergence of seedlings and observed for morphological characteristics like plant height, root proliferation and fruit yield.
2.6 Statistical Analysis
The results were subjected to analysis of variance (ANOVA) using IBM SPSS Statistics 21 and evaluated for the significance of the results obtained.
3 Results and Discussion
3.1 Isolation and Molecular Characterization of Bacillus sp.
A total of 7 different bacterial colonies were observed in nutrient agar plates out of which only one was observed to be gram-positive rod (designated as CUAMS116) and selected for further biochemical characterization (Fig. 1). The significant reduction in the number of bacterial colonies is attributed to the heating step involved in screening of Bacillus sp. The results of the biochemical profiling of isolate CUAMS116 are presented in Table 2. The results of biochemical tests tentatively confirmed the isolate to be B. cereus. The percentage of gene similarity as evident from BLAST is represented in Fig. 2. The strain was identified to be B. cereus CUAMS116, and the sequence was submitted to GenBank (Accession No: MN093299). The phylogenetic tree depicting the evolutionary relationship of the isolate was created using ClustalW and MEGA 6 software (Fig. 2).
3.2 In Vitro Screening for Growth-Promoting Traits
3.2.1 Siderophore Production Test
Iron (Fe) is an essential micronutrient for plants as well as micro-organisms. Iron plays a major role in important biological processes like photosynthesis, respiration, chlorophyll biosynthesis [31] and biological nitrogen fixation [32]. These strategies favour the bacteria in overcoming the nutritional Fe limitation with the help of chelator agents referred to as siderophores. Siderophores are defined as low molecular mass molecules (< 1000 Da) with high specificity and affinity for chelating or binding Fe3+ that are involved in the transportation and deposition of Fe within bacterial cells [33, 34]. The bacterial isolate B. cereus CUAMS116 showed positive results for siderophore production (Fig. 3a). Hence, the isolate possesses the ability to sequester and solubilize iron which is an important character of PGPM.
In vitro plant growth-promoting traits exhibited by the isolate Bacillus cereus CUAMS116; a siderophore production test: the appearance of reddish colour in the test tubes containing the culture indicated a positive result. b IAA production test: absence of cherry red coloured ring marked the culture to be negative for IAA production. c Phosphate solubilization test: moderate phosphate solubilization activity exhibited by test culture as evident from narrow zone of clearance. d Cellulase production test: clear zone of hydrolysis in CMC agar plates reflected the culture to be positive for cellulase production. e HCN production test: the colour change of filter paper indicated moderate HCN production. f Ammonia production test: development of brown colour in test tube inoculated with bacterial culture indicated it to be positive for ammonia production test. g Bioassay against fungal pathogens: the bacterial strain was observed to have no significant activity against tested fungal pathogen
Many researches have been conducted on the production of siderophores, largely by the plant-associated bacterial strains. This characteristic was found to be the most common trait in the isolates associated with growth enhancement in sunflowers (Helianthus annuus L.) [35] and rice [36]. In rice roots, the siderophore production by isolates belonging to genera Enterobacter and Burkholderia was also found to be in appreciably higher levels [36, 37]. Along with the genera Burkholderia, Enterobacter, Grimontella also include strains with high siderophore production. The excretion of siderophores by bacteria can stimulate plant growth either directly by improving nutrition or indirectly by inhibiting the establishment of phytopathogens through Fe sequestration from the immediate environment.
The endophytic strains in maize, belonging to genus Bacillus, have been observed with different plant growth-promoting characteristics, such as siderophore production. The effectivity was pronounced in its activity against the growth of Fusarium verticillioides, Colletotrichum graminicola, Bipolaris maydis and Cercospora zea-maydis fungi [38].
3.2.2 IAA Production
Enhancement of soil fertility and plant productivity by isolation of indole acetic acid producing PGPM and its application on crops is a promising way to increase soil fertility and plant productivity [39]. Reports suggest various mechanisms by which PGPR exert beneficial effects on plants which includes facilitated uptake of nutrients such as phosphorus via phosphate solubilization and synthesizing growth stimulatory phytohormones like indole-3-acetic acid (IAA) [40]. IAA production by many rhizospheric microbes in culture media, with or without the addition tryptophan, had been studied. These include bacteria which are consistently used as inoculants. Exudates from roots are reported to contain tryptophan or related compounds. These compounds act as precursors for IAA synthesis, and the roots take up this as indoles. Microbial production of IAA in the root zone therefore provides an exogenous source of hormone. The plants which hosted epiphytic bacteria were assessed with more endogenous auxin than those maintained in sterile, controlled conditions. Following the process of bacterization, growth enhancement in terms of improved rooting of cuttings and enlargement or stunting of primary roots observed were partly explained on the basis of IAA synthesis occurred in the rhizosphere [41]. The bacterial isolate B. cereus CUAMS116 showed negative results for IAA production (Fig. 3b). Mohite [42] has reported the variations in IAA production by various bacterial strains depending on the culture conditions provided, substrate availability and growth stages. The production was found to be negligible or even nil in media which lacked L-tryptophan.
3.2.3 Phosphate Solubilization test
Phosphorus (P) is an essential mineral element in plants whose deficiency or nonavailability can have a limiting impact on plant growth as in the case of nitrogen. Naturally, these minerals are relatively abundant in soils in both organic and inorganic forms [43]. But the large reservoir of P may not always suffice the amount of plant available forms. The major reason for low availability is due to the insoluble forms in which the majority of soil P usually exist. Absorption by plants can happen only in two soluble forms, either as monobasic HPO4 or as dibasic H2PO4 ions forms. Inorganic minerals like apatite contain insoluble P. It can also occur as one of the several organic forms including inositol phosphate (soil phytate), phosphomonoesters and phosphotriester forms [43].
Under this scenario, phosphate-solubilizing micro-organisms (PSM) are employed to provide the available forms of P to the plants [28]. Various soil bacteria possess the ability to produce low molecular weight organic acids that act on the inorganic phosphorus and help in its solubilization forms [43]. Conversely, the mineralization of organic phosphorus occurs through the synthesis of a variety of different phosphatases, catalysing the hydrolysis of phosphoric esters forms [43]. Phosphate solubilization and mineralization traits are also found to be coexisting in the same bacterial strain [44]. The bacterial isolate B. cereus CUAMS116 showed moderate level of phosphate solubilization activity (Fig. 3c). The beneficial effects of the inoculation with PSB alone or in combination with other rhizospheric microbes have been reported through many works [45]. Along with the function enabling P availability to the plants, the phosphate-solubilizing bacteria also augment the growth of plants by stimulating the efficiency of BNF, enhancing the availability of other trace elements by synthesizing important plant growth-promoting substances [43].
3.2.4 Test for Cellulase Production
Extracellular enzymes (chitinases, pectinases, cellulases, glucanases and proteases) are associated with biocontrol abilities of the PGPM strains [46]. These enzymes degrade fungal cell walls and protect plants from phytopathogens. In addition to this, cellulase and pectinase activities are useful in degrading plant cell wall structures which help PGPM to colonize in plant tissues and root systems. PGPM-producing extracellular enzymes in combination with other biocontrol agents lead to synergistic inhibitory effect against pathogens [47]. Inoculation of the B. cereus CUAMS116 on CMC plates produced a clear zone of hydrolysis upon incubation (Fig. 3d), indicating the presence of extracellular cellulase enzymes.
3.2.5 Test for HCN Production
HCN production is a usual strategy for the antagonistic activity of PGPM. HCN is produced by oxidative decarboxylation directly from precursors like glutamate, glycine or methionine [48]. It is a volatile secondary metabolite that plays a major role in biological control of many soil-borne diseases [49]. At extremely low concentrations cyanide affects the aerobic organisms, while the producer organisms are resistant [50]. In the present study the bacterial isolate B. cereus CUAMS116 was found not to have significant HCN production ability (Fig. 3e). This signifies that plant growth promotion by the isolate can take place through any other methods apart from HCN production. HCN is a powerful inhibitor of many metal enzymes, especially copper containing cytochrome C-oxidases. HCN is formed from glycine through the action of HCN synthetase associated with the plasma membrane of certain rhizobacteria [51]. Bhatt and Vyas (2014) [26] have reported bacterial isolates that showed many of the plant growth-promoting traits except HCN production. HCN production is mostly correlated with antagonistic properties of bacteria. Thus, the isolate may be considered less potent against phytopathogens.
3.2.6 Test for Ammonia Production
Ammonia produced by diazotrophs is one of the most significant characteristics of PGPM which benefits the plants [26, 52]. The subsequent increase in soil pH creating an alkaline condition (pH 9–9.5) suppresses the growth of certain fungi and nitrobacteria due to its potent inhibition effect. It also upsets the microbial community and inhibits germination of spores of many fungi [53]. In the present study the bacterial isolate B. cereus CUAMS116 was found to be positive for ammonia production (Fig. 3f). Christiansen et al. [54] have reported that the level of oxygen in aerobic conditions was the same as the level of ammonia excretion under oxygen-limiting conditions. However, Joseph et al. [55] reported ammonia production in 95% of isolates of Bacillus followed by Pseudomonas (94.2%), Rhizobium (74.2%) and Azotobacter (45%).
3.2.7 Bioassay Against Fungal Pathogens
Although many B. cereus strains have been reported for its biocontrol potential, in the present study the strain B. cereus CUAMS116 failed to exhibit any significant inhibitory effect on the tested fungal pathogens (Fig. 3g). This could be interpreted as the strain’s inability to produce sufficient concentrations of the inhibitory enzymes required to prevent the growth of fungus in a favourable environment for the latter [4].
3.3 Greenhouse Trials
The results of pot culture experiment to study the effectiveness of B. cereus CUAMS116 inoculated as liquid inoculant on growth, yield and root proliferation of Phaseolus vulgaris L. under pot culture conditions are presented in Table 3.
The effect of inoculation of B. cereus CUAMS116 strain on plant height under pot culture condition was recorded at 5, 15, 30 days after treatment and at harvest. Initially, on the 5th day after treatment (DAT) with the isolate, the mean height of control plants was found to be 14.48 cm and that of treated plants was found to be 14.5 cm. Thus, an increase of 0.13% was observed by the treatment when compared with uninoculated control plants. Similarly, when measured on 15th DAT, the control measured 16.34 cm and treated plants measured 19.05 cm, showing 16.58% increase in length. At 30 DAT, the percentage increase was found to be 47.32, with the control plants measuring on an average 16.61 cm and treated plants measuring 24.47 cm. At the harvest stage, the mature control plants measured 16.53 cm and mean treated plant height was measured to be 27.75 cm, showing a maximum percentage increase in length of 67.87% (Fig. 4). The results are comparable with the study of Yolcu et al. [56] to assess the effects of 12 PGPM isolates including 5 Bacillus species on the morphology and yield of Hungarian vetch (Vicia pannonica Crantz.) which showed notably different plant heights than the controls. Analysis of variance conducted on the influence of inoculation with B. cereus CUAMS116 in various concentrations on the plant heights of Phaseolus vulgaris L. shows a significant (p ≤ 0.05) effect. The effect of inoculation with B. cereus CUAMS116 in root proliferation of the P. vulgaris L. grown under greenhouse conditions was assessed at the time of harvest (Fig. 5). A significant root proliferation was visualized in the plants inoculated with the isolate which showed increased number of lateral roots that formed a dense mat, thereby helping in better absorption of water and nutrients from soil. The results thus obtained can be compared with the works reported by Akinrinlola et al. [18]. Four out of five Bacillus strains tested, increased growth significantly in Soybean when compared to the control, and root growth was stimulated up to 144%. When tested on wheat, significant growth was observed to be induced by three out of five Bacillus strains in treated plants. Over the controls, root growth simulations were as high as 154% over the controls.
The maximum yield of 6 fruits per plant was recorded from 100% inoculum treatment. The fruit yields varied on an average of 3–5 per plant in rest of the treatments. Treatment with PGPM like Rhizobium alone or with other similar inoculants has been reported to increase the polysaccharide content in soil and the plant dry weight in leguminous crops like chickpea, lentil and pea [57]. Field studies conducted with four B. subtilis isolates like B. subtilis MTCC-2422, B. subtilis KU936344, B. subtilis KU936345 and B. subtilis KU936341, have shown a significant reduction in late blight disease incidence and increased like plant height, sprouting, number of leaves, fresh weight and dry weight of plants [58]. All these results are suggestive of the potential of bacterial strains in plant growth promotion.
4 Conclusion
The present work isolated and characterized a plant growth-promoting bacteria and studied its efficacy as a microbial inoculant on Phaseolus vulgaris L., under pot culture conditions. From the results obtained, it can be inferred that the isolated strain B. cereus CUAMS116 is capable of promoting the plant growth at conditions almost comparable to the usual field conditions. In vitro screening tests for growth-promoting traits have revealed several positive results as in the isolates ability for siderophore production, phosphate solubilization, ammonia production and cellulase production. Greenhouse pot trials have also shown the inoculant’s potential to enhance plant growth, as evidenced by the increase in plant heights, significant root proliferation and preventing premature fall of flowers that help them to fully develop till the fruiting stage, hence promising economical returns. The root proliferation indicates a larger root surface that aids in better water acquisition and nutrient uptake. These characteristics in a way are suggestive of the inoculants potential to help the plant to mitigate abiotic stresses perhaps due to changing climate.
References
Walker, T.S.; Bais, H.P.; Grotewold, E.; Vivanco, J.M.: Root exudation and rhizosphere biology. Plant Physiol. 132, 44–51 (2003). https://doi.org/10.1104/pp.102.019661
Zablotowicz, R.M.; Tipping, E.M.; Lifshitz, R.; Kloepper, J.W.: Plant growth promotion mediated by bacterial rhizosphere colonizers. In: Keister, D.L., Cregan, P.B. (eds.) The Rhizosphere and Plant Growth. Beltsville Symposia in Agricultural Research. Springer, Dordrecht (1991). https://doi.org/10.1007/978-94-011-3336-4_70
Compant, S.; Samad, A.; Faist, H.; Sessitsch, A.: A review on the plant microbiome: ecology, functions, and emerging trends in microbial application. J. Adv. Res. 19, 29–37 (2019). https://doi.org/10.1016/j.jare.2019.03.004
Glick, B.R.: Plant growth-promoting bacteria: mechanisms and applications. Scientifica 2012, 963401 (2012). https://doi.org/10.6064/2012/963401
Compant, S.; Duffy, B.; Nowak, J.; Clément, C.; Barka, E.A.: Use of plant growth-promoting bacteria for biocontrol of plant diseases: principles, mechanisms of action, and future prospects. Appl. Environ. Microbiol. 71, 4951–4959 (2005). https://doi.org/10.1128/AEM.71.9.4951-4959.2005
Kloepper, J.W.: Plant growth-promoting rhizobacteria and plant growth under gnotobiotic conditions. Phytopathology 71, 642–644 (1981). https://doi.org/10.1094/phyto-71-642
Anderson, A.J.: Responses of bean to root colonization with Pseudomonas putida in a hydroponic system. Phytopathology 75, 992–995 (1985). https://doi.org/10.1094/phyto-75-992
Bahme, J.B.; Schroth, M.N.; Van Gundy, S.D.; Weihold, A.R.; Tolentino, D.M.: Effect of inocula delivery systems on rhizobacterial colonization of underground organs of potato. Phytopathology 78, 534–542 (1988)
Yadav, B.K.; Akhtar, M.S.; Panwar, J.: Rhizospheric plant-microbe interactions: key factors to soil fertility and plant nutrition. In: Arora, N. (ed.) Plant Microbes Symbiosis: Applied Facets. Springer, New Delhi (2015). https://doi.org/10.1007/978-81-322-2068-8_6
Stamenković, S.; Beškoski, V.; Karabegović, I.; Lazić, M.; Nikolić, N.: Microbial fertilizers: a comprehensive review of current findings and future perspectives. Span. J. Agric. Res. 16, e09R01 (2018). https://doi.org/10.5424/sjar/2018161-12117
Kaminsky, L.M.; Trexler, R.V.; Malik, R.J.; Hockett, K.L.; Bell, T.H.: The inherent conflicts in developing soil microbial inoculants. Trends Biotechnol. 37, 140–151 (2019). https://doi.org/10.1016/j.tibtech.2018.11.011
Botelho, G.R.; Mendonça-Hagler, L.C.: Fluorescent Pseudomonads associated with the rhizosphere of crops: an overview. Braz. J. Microbiol. 37, 401–416 (2006). https://doi.org/10.1590/s1517-83822006000400001
Barrett, R.D.H.; MacLean, R.C.; Bell, G.: Experimental evolution of Pseudomonas fluorescens in simple and complex environments. Am. Nat. 166, 470–480 (2005). https://doi.org/10.1086/444440
Brown, M.E.: Seed and root bacterization. Annu. Rev. Phytopathol. 12, 181–197 (1974). https://doi.org/10.1146/annurev.py.12.090174.001145
Niu, D.-D.; Liu, H.-X.; Jiang, C.-H.; Wang, Y.-P.; Wang, Q.-Y.; Jin, H.-L.; Guo, J.-H.: The plant growth-promoting rhizobacterium Bacillus cereus AR156 induces systemic resistance in Arabidopsis thaliana by simultaneously activating salicylate- and jasmonate/ethylene-dependent signaling pathways. Mol. Plant Microbe Interact. 24, 533–542 (2011). https://doi.org/10.1094/MPMI-09-10-0213
Niu, D.-D.; Wang, C.-J.; Guo, Y.-H.; Jiang, C.-H.; Zhang, W.-Z.; Wang, Y.-P.; Guo, J.-H.: The plant growth-promoting rhizobacterium Bacillus cereus AR156 induces resistance in tomato with induction and priming of defence response. Biocontrol Sci. Technol. 22(9), 991–1004 (2012). https://doi.org/10.1080/09583157.2012.706595
Hassan, T.; Naz, I.; Hussain, M.: Bacillus cereus: a competent plant growth promoting bacterium of saline sodic field. Pak. J. Bot. 50, 1029–1037 (2018)
Akinrinlola, R.J.; Yuen, G.Y.; Drijber, R.A.; Adesemoye, A.O.: Evaluation of Bacillus strains for plant growth promotion and predictability of efficacy by in vitro physiological traits. Int. J. Microbiol. (2018). https://doi.org/10.1155/2018/5686874
Zeng, Q.; Xie, J.; Li, Y.; Gao, T.; Xu, C.; Wang, Q.: Comparative genomic and functional analyses of four sequenced Bacillus cereus genomes reveal conservation of genes relevant to plant-growth-promoting traits. Sci. Rep. 8, 17009 (2018). https://doi.org/10.1038/s41598-018-35300-y
Calvo, P.; Watts, D.B.; Kloepper, J.W.; Torbert, H.A.: Application of microbial-based inoculants for reducing N2O emissions from soil under two different ammonium nitrate-based fertilizers. Soil Sci. (2016). https://doi.org/10.1097/SS.0000000000000176
Kumar, A.; Kumar, A.; Devi, S.; Patil, S.; Payal, C.; Negi, S.: Isolation, screening and characterization of bacteria from Rhizospheric soils for different plant growth promotion (PGP) activities: an in vitro study. Recent Res. Sci. Technol. 4(1), 1–5 (2012)
Lugtenberg, B.; Kamilova, F.: Plant-growth-promoting rhizobacteria. Annu. Rev. Microbiol. 63, 541–556 (2009). https://doi.org/10.1146/annurev.micro.62.081307.162918
Jatav, P.; Gupta, A.; Singh Ahirwar, S.; Jatav, S.; Jatav, A.; Kushwaha, K.: Production of plant growth hormones indole-3-acetic acid (IAA) using bacillus by batch fermentation. GJBB 6, 612–616 (2017)
Nautiyal, C.S.; Shekhar Nautiyal, C.: An efficient microbiological growth medium for screening phosphate solubilizing microorganisms. FEMS Microbiol. Lett. 170(1), 265–270 (1999). https://doi.org/10.1111/j.1574-6968.1999.tb13383.x
Afsharmanesh, H.: Characterization of the antagonistic activity of a new indigenous strain of Pseudomonas fluorescens isolated from onion rhizosphere. JPP 92, 187–194 (2010)
Bhatt, P.: Screening and characterization of plant growth and health promoting rhizobacteria. Int. J. Curr. Microbiol. Appl. Sci. 3, 139–155 (2014)
Bakker, A.W.; Schippers, B.: Microbial cyanide production in the rhizosphere in relation to potato yield reduction and Pseudomonas SPP-mediated plant growth-stimulation. Soil Biol. Biochem. 19, 451–457 (1987). https://doi.org/10.1016/0038-0717(87)90037-x
Ahemad, M.; Kibret, M.: Mechanisms and applications of plant growth promoting rhizobacteria: current perspective. J. King Saud Univ. Sci. 26, 1–20 (2014). https://doi.org/10.1016/j.jksus.2013.05.001
Ajay, K.; Amit, K.; Shikha, D.; Sandip, P.; Chandani, P.; Sushila, N.: Isolation, screening and characterization of bacteria from Rhizospheric soils for different plant growth promotion (PGP) activities: an in vitro study. Res. Sci. 4, 1–5 (2012). https://doi.org/10.1007/s13213-014-0977-x
Amalraj, L.D.: Effect of polymeric additives, adjuvants, surfactants on survival, stability and plant growth promoting ability of liquid bioinoculants. J. Plant Physiol. Pathol. (2013). https://doi.org/10.4172/2329-955x.1000105
Kobayashi, T.; Nishizawa, N.K.: Iron uptake, translocation, and regulation in higher plants. Plant Cell Physiol. 28, 1081–1092 (2012). https://doi.org/10.1146/annurev-arplant-042811-105522
Dixon, R.; Kahn, D.: Genetic regulation of biological nitrogen fixation. Nat. Rev. Microbiol. 2, 621–631 (2004). https://doi.org/10.1038/nrmicro954
Neilands, J.B.: Siderophores: structure and function of microbial iron transport compounds. J. Biol. Chem. 270, 26723–26726 (1995). https://doi.org/10.1074/jbc.270.45.26723
Krewulak, K.D.; Vogel, H.J.: Structural biology of bacterial iron uptake. Biochimica et Biophysica Acta (BBA)-Biomembranes 1778, 1781–1804 (2008). https://doi.org/10.1016/j.bbamem.2007.07.026
Ambrosini, A.; Beneduzi, A.; Stefanski, T.; Pinheiro, F.G.; Vargas, L.K.; Passaglia, L.M.P.: Screening of plant growth promoting Rhizobacteria isolated from sunflower (Helianthus annuus L.). Plant Soil 356, 245–264 (2012). https://doi.org/10.1007/s11104-011-1079-1
de Souza, R.; de Souza, R.; Beneduzi, A.; Ambrosini, A.; da Costa, P.B.; Meyer, J.; Vargas, L.K.; Schoenfeld, R.; Passaglia, L.M.P.: The effect of plant growth-promoting rhizobacteria on the growth of rice (Oryza sativa L.) cropped in southern Brazilian fields. Plant Soil 366, 585–603 (2013). https://doi.org/10.1007/s11104-012-1430-1
de Souza, R.; de Souza, R.; Meyer, J.; Schoenfeld, R.; da Costa, P.B.; Passaglia, L.M.P.: Characterization of plant growth-promoting bacteria associated with rice cropped in iron-stressed soils. Ann. Microbiol. 65, 951–964 (2015). https://doi.org/10.1007/s13213-014-0939-3
Szilagyi-Zecchin, V.J.; Ikeda, A.C.; Hungria, M.; Adamoski, D.; Kava-Cordeiro, V.; Glienke, C.; Galli-Terasawa, L.V.: Identification and characterization of endophytic bacteria from corn (Zea mays L.) roots with biotechnological potential in agriculture. AMB Express. 4, 26 (2014). https://doi.org/10.1186/s13568-014-0026-y
Vejan, P.; Abdullah, R.; Khadiran, T.; Ismail, S.; Nasrulhaq Boyce, A.: Role of plant growth promoting rhizobacteria in agricultural sustainability—a review. Molecules (2016). https://doi.org/10.3390/molecules21050573
Vessey, J.K.: Plant growth promoting rhizobacteria as biofertilizers. Plant Soil 255, 571–586 (2003). https://doi.org/10.1023/A:1026037216893
Libbert, E.; Manteuffel, R.: Interactions between plants and epiphytic bacteria regarding their auxin metabolism: VII. The influence of the epiphytic bacteria on the amount of diffusible auxin from corn coleoptiles. Physiol Plant. 23, 93–98 (1970). https://doi.org/10.1111/j.1399-3054.1970.tb06395.x
Mohite, B.: Isolation and characterization of indole acetic acid (IAA) producing bacteria from rhizospheric soil and its effect on plant growth. J. Soil Sci. Plant Nutr. 13, 638–649 (2013). https://doi.org/10.4067/s0718-95162013005000051
Khan, M.S.; Zaidi, A.; Wani, P.A.; Oves, M.: Role of plant growth promoting rhizobacteria in the remediation of metal contaminated soils. Environ. Chem. Lett. 7, 1–19 (2009)
Tao, G.-C.; Guang-Can, T.A.O.; Tian, S.-J.; Miao-Ying, C.A.I.; Guang-Hui, X.I.E.: Phosphate-solubilizing and -mineralizing abilities of bacteria isolated from soils. Pedosphere 18, 515–523 (2008). https://doi.org/10.1016/s1002-0160(08)60042-9
Zaidi, A.; Khan, S.: Interactive effect of rhizotrophic microorganisms on growth, yield, and nutrient uptake of wheat. J. Plant Nutr. 28(12), 2079–2092 (2005). https://doi.org/10.1080/01904160500320897
El-Tarabily, K.A.: Promotion of tomato (Lycopersicon esculentum Mill.) plant growth by rhizosphere competent 1-aminocyclopropane-1-carboxylic acid deaminase-producing streptomycete actinomycetes. Plant Soil 308, 161–174 (2008). https://doi.org/10.1007/s11104-008-9616-2
Someya, N.; Tsuchiya, K.; Sugisawa, S.; Noguchi, M.T.; Yoshida, T.: Growth promotion of lettuce (Lactuca sativa L.) by a rhizobacterium Pseudomonas fluorescens strain LRB3W1 under iron-limiting condition. Environ. Control Biol. 46, 139–146 (2008). https://doi.org/10.2525/ecb.46.139
Muthezhilan, R.; Sindhuja, B.S.; Hussain, A.J.; Jayaprakashvel, M.: Efficiency of plant growth promoting rhizobacteria isolated from sand dunes of Chennai coastal area. Pak. J. Biol. Sci. 15, 795–799 (2012). https://doi.org/10.3923/pjbs.2012.795.799
Trivedi, P.; Pandey, A.: Plant growth promotion abilities and formulation of Bacillus megaterium strain B 388 (MTCC6521) isolated from a temperate Himalayan location. Indian J. Microbiol. 48, 342–347 (2008). https://doi.org/10.1007/s12088-008-0042-1
Anand, R.; Kulothungan, S.: Antifungal metabolites of Pseudomonas fluorescens against crown rot pathogen of Arachis hypogaea. Ann. Biol. Res. 1, 199–207 (2010)
Blumer, C.; Heeb, S.; Pessi, G.; Haas, D.: Global GacA-steered control of cyanide and exoprotease production in Pseudomonas fluorescens involves specific ribosome binding sites. Proc. Natl. Acad. Sci. USA 96, 14073–14078 (1999). https://doi.org/10.1073/pnas.96.24.14073
Selvakumar, G.; Kundu, S.; Gupta, A.D.; Shouche, Y.S.; Gupta, H.S.: Isolation and characterization of nonrhizobial plant growth promoting bacteria from nodules of Kudzu (Pueraria thunbergiana) and their effect on wheat seedling growth. Curr. Microbiol. 56, 134–139 (2008). https://doi.org/10.1007/s00284-007-9062-z
Marschner, H.; Römheld, V.; Horst, W.J.; Martin, P.: Root-induced changes in the rhizosphere: importance for the mineral nutrition of plants. Zeitschrift für Pflanzenernährung und Bodenkunde 149, 441–456 (1986). https://doi.org/10.1002/jpln.19861490408
Christiansen, J.S.; Jørgensen, E.H.; Jobling, M.: Oxygen consumption in relation to sustained exercise and social stress in Arctic charr (Salvelinus alpinus L.). J. Exp. Zool. 260, 149–156 (1991). https://doi.org/10.1002/jez.1402600203
Joseph, B.; Ranjan Patra, R.; Lawrence, R.: Characterization of plant growth promoting rhizobacteria associated with chickpea (Cicer arietinum L.). Int. J. Plant Prod. 1, 141–152 (2012). https://doi.org/10.22069/ijpp.2012.532
Yolcu, H.; Adem, G.; Gullap, K.M.; Cakmakci, R.: Effects of plant growth-promoting rhizobacteria on some morphologic characteristics, yield and quality contents of Hungarian Vetch. Turk. J. Field Crops. 17, 208–214 (2012)
Babu, S.; Prasanna, R.; Bidyarani, N.; Nain, L.; Shivay, Y.S.: Synergistic action of PGP agents and Rhizobium spp. for improved plant growth, nutrient mobilization and yields in different leguminous crops. Biocatal. Agric. Biotechnol. 4, 456–464 (2015). https://doi.org/10.1016/j.bcab.2015.09.004
Kumbar, B.; Mahmood, R.; Nagesha, S.N.; Nagaraja, M.S.; Prashant, D.G.; Kerima, O.Z.; Karosiya, A.; Chavan, M.: Field application of Bacillus subtilis isolates for controlling late blight disease of potato caused by Phytophthora infestans. Biocatal. Agric. Biotechnol. 22, 101366 (2019). https://doi.org/10.1016/j.bcab.2019.101366
Acknowledgements
Authors are indebted to the Department of Life Sciences, CHRIST (Deemed to be University), Bengaluru, Karnataka, India, and the Department of Microbial Biotechnology, Bharathiar University, Coimbatore, Tamil Nadu, India, for providing the necessary facilities to execute the planned research work. Authors also acknowledge Barcode Biosciences, Bangalore, Karnataka, India, for providing 16S rRNA Sequencing facility.
Funding
This research did not receive any specific grant from funding agencies in the public, commercial or not-for-profit sectors.
Author information
Authors and Affiliations
Corresponding author
Ethics declarations
Conflict of interest
The authors declare no conflict of interest.
Electronic supplementary material
Below is the link to the electronic supplementary material.
Rights and permissions
About this article
Cite this article
Sebastian, A.M., Umesh, M., Priyanka, K. et al. Isolation of Plant Growth-Promoting Bacillus cereus from Soil and Its Use as a Microbial Inoculant. Arab J Sci Eng 46, 151–161 (2021). https://doi.org/10.1007/s13369-020-04895-8
Received:
Accepted:
Published:
Issue Date:
DOI: https://doi.org/10.1007/s13369-020-04895-8